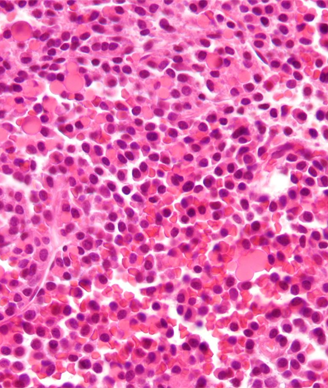

Multiple Myeloma
Latest News
Latest Videos

CME Content
More News

The FDA has expanded the use of oral lenalidomide in multiple myeloma to include its use in combination with dexamethasone for newly diagnosed patients.

A scoring system that measured frailty in elderly patients with multiple myeloma was able to accurately predict mortality and risk of toxicity.

The International Myeloma Working Group recently published a series of consensus statements discussing the use of MRI in the treatment of multiple myeloma.

A new trial reported improved overall survival in myeloma patients who received a higher bortezomib dose as part of a bortezomib/melphalan/prednisone regimen.

Cigarette smoking is not a risk factor for multiple myeloma, according to the results of a pooled analysis of nine case-control studies.

The addition of daratumumab to traditional therapies used in the treatment of multiple myeloma was well tolerated and associated with high rates of responses.

Early trial data support further evaluation of ixazomib combined with lenalidomide and dexamethasone for the treatment of newly diagnosed multiple myeloma.

Survivors of multiple myeloma and pancreatic cancer may have some of the poorest physical health-related quality of life outcomes, according to a new study.

Patients who experienced early relapse of multiple myeloma after undergoing autologous stem cell transplantation had worse progression-free and overall survival.

Myeloma patients treated with melphalan prior to transplant had reductions in chemo-induced nausea/vomiting when given granisetron/dexamethasone and aprepitant.

Panobinostat added to bortezomib/dexamethasone for treating relapsed/refractory multiple myeloma improved progression-free survival and complete response rates.

Multiple myeloma patients may already suffer from sensory deficits prior to treatment, likely due to disease-related decreases in peripheral innervation density.
The optimal treatment strategy for newly diagnosed multiple myeloma is consolidation with melphalan, stem-cell transplantation, then lenalidomide maintenance.

Continuous treatment with lenalidomide plus dexamethasone improved progression-free and overall survival in transplant-ineligible multiple myeloma patients.

Treatment with bortezomib prior to autologous stem cell transplant resulted in superior outcomes in multiple myeloma patients with end-stage renal failure.

In a phase I trial, the oral AKT inhibitor afuresertib demonstrated single-agent activity against hematologic malignancies, specifically multiple myeloma.

Researchers from Japan believe they have identified a novel staging system based on hemoglobin and plasmacytoma that may help to stratify patients with multiple myeloma who are treated with novel therapeutics.

Carfilzomib given at a higher dose as a slow intravenous infusion over 30 minutes resulted in a very high response rate in a heavily pretreated myeloma population.

A comparison of melphalan, prednisone plus either thalidomide or lenalidomide found that patients assigned to lenalidomide had fewer grade 3 or higher toxicities and a better quality of life at the end of induction therapy.

Treatment of relapsed or refractory multiple myeloma with the three-drug combination of panobinostat/bortezomib/dexamethasone resulted in a nearly 4-month improvement in progression-free survival compared to treatment with bortezomib/dexamethasone alone.

A phase II trial of propylene glycol-free melphalan in patients with multiple myeloma has met its primary endpoint, according to a statement released by the drug manufacturer.

The NICE announced that newly diagnosed multiple myeloma patients will be guaranteed access to treatment with the proteasome inhibitor bortezomib (Velcade).

The novel experimental drug sotatercept increased bone mineral density and bone formation in patients with osteolytic lesions of multiple myeloma who had not used bisphosphonates, a phase II study showed.

Results of a new study indicate that half of patients with multiple myeloma were referred to specialist palliative care.

The combination of bortezomib, lenalidomide, and dexamethasone resulted in a partial response or better in more than 60% of patients with relapsed or refractory multiple myeloma, according to results of a phase II trial.










































